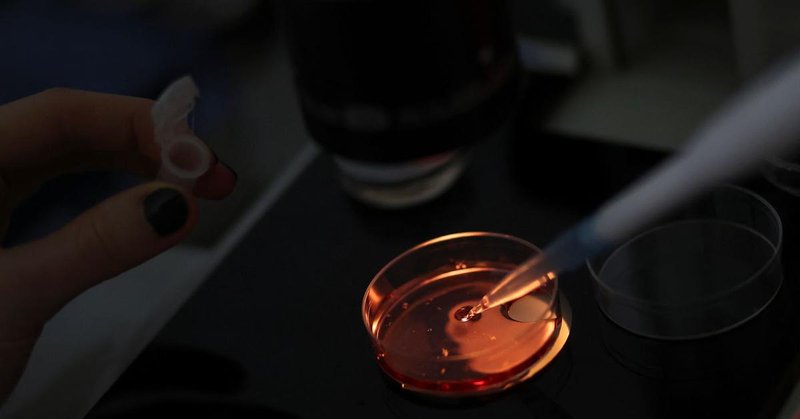
Tweet card summary image

Semafor
@semafor
Followers
72K
Following
72
Media
2K
Statuses
25K
A global intelligence news platform for the new world economy. Sign up for our email briefings: https://t.co/2UKZtXI7cl
Joined May 2008
🟡 @PBS CEO Paula Kerger joins Mixed Signals at a moment when public broadcasting is facing its most existential threat in decades. @maxwelltani and @semaforben ask her about the political onslaught from the Trump administration and Congress, what losing federal support will
1
2
4
Asked how he thinks about President Trump's recent pardons, US Attorney Jay Clayton tells @lizrhoffman: "The president has the final word."
2
4
19
French AI startup Mistral goes small with stronger AI models https://t.co/baUv99UsDX
semafor.com
The smallest of the new models is tiny by LLM standards, but the company says it can outperform some models four times its size.
0
0
2
Airbus stock soars despite issues with bestselling jet https://t.co/KJP6B1luOb
semafor.com
The European aircraft manufacturer said new A320s required additional checks, compounding challenges for the firm.
0
0
0
Scientists find gene associated with schizophrenia https://t.co/fctEDAkBIC
semafor.com
The idea of a single gene for complex traits — whether height, intelligence, mental health, or sexuality — has largely fallen away.
1
0
0
Two Omani green hydrogen projects end https://t.co/zssoteEMAZ
semafor.com
The decision comes amid industry concerns about a mismatch between supply and demand for the low-emissions fuel.
0
0
1
“This is solely about book sales and revenge — book sales for her and revenge for him, and there’s zero upside in engaging here…Bobby and [wife] Cheryl and the administration moved on from this a year ago.” RFK Jr keeps out of the Lizza-Nuzzi feud: https://t.co/O9fC2tgds8
semafor.com
The man in the middle of 2025’s most lurid political-media storm seems intent on riding it out quietly.
2
4
9
South Africa records stronger-than-expected GDP growth https://t.co/SSoMk9qKlV
semafor.com
The 0.5% growth, compared with the previous three months, marks a fourth straight quarter of expansion.
0
0
0
Nigeria nominates new defense minister https://t.co/HJ9RY35Dhv
semafor.com
The move comes against the backdrop of a security crisis that threatens bilateral ties with the US.
0
0
0
Trump escalates showdown with Venezuela https://t.co/Cknm4fmRUw
semafor.com
Trump on Tuesday said he would soon start land strikes inside Venezuela, despite facing blowback over lethal attacks on suspected drug boats.
0
0
2
Listen to the full interview on Mixed Signals from Semafor Media: https://t.co/YQiEIYpfif
0
0
0
"Didn't you understand that if you were not funding it, it probably wasn't going to exist? @PBS CEO Paula Kerger tells @semaforben and @maxwelltani that some lawmakers were surprised by the fallout from defunding public broadcasting.
3
2
5
Senate unlikely to get health care deal before key vote https://t.co/FgzAlleTK7
semafor.com
Senators are still searching for an elusive bipartisan deal to prevent the Affordable Care Act’s enhanced tax credits from expiring.
0
1
0
Cornyn trails Paxton in Texas Senate race, Democratic poll finds https://t.co/xqaBaJCfow
semafor.com
Sen. John Cornyn is widely seen as a more electable general candidate than Ken Paxton.
0
0
3
🟡 @WioBank CEO Jayesh Patel will join Semafor's The Next 3 Billion in Abu Dhabi on Dec. 11 to discuss sustainable finance, digital transformation, and cross-border collaboration. Request an invitation: https://t.co/hQozucq9Qk
0
0
0
More Americans concerned about political rhetoric, poll finds https://t.co/VBHKKCmysx
semafor.com
Majorities say both parties’ rhetoric has “gone too far.”
0
0
0
Anthropic reportedly preparing for IPO https://t.co/r6M34mYoAh
semafor.com
The AI firm’s IPO would be among the largest ever.
0
0
1
Families of Kenyans fighting for Russia demand their return https://t.co/RcgdwKPM61
semafor.com
Nairobi said around 200 Kenyans are fighting alongside Russian forces in the country’s war against Ukraine.
1
0
3
Putin says Russia ‘ready’ for war with Europe https://t.co/AnPk1yHhUo
semafor.com
Five hours of negotiations involving US President Donald Trump’s envoy and his son-in-law did not result in a compromise, a Putin aide said.
0
1
1
France's Macron in China to talk trade, tech https://t.co/FCfYthX6uW
semafor.com
Macron’s trip is part of a European push to reduce tensions with the world’s second-biggest economy.
0
0
2